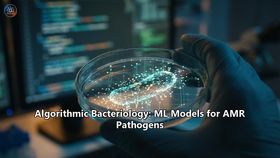
Algorithmic Bacteriology: ML Models for AMR Pathogens

Algorithmic Bacteriology: ML Models for AMR Pathogens
The silent pandemic of Antimicrobial Resistance (AMR) is one of the most profound public health crises in human history. In 2019, AMR was directly responsible for approximately 1.3 million deaths globally—a toll greater than HIV/AIDS or malaria—and if current trends hold, that number is projected to ...